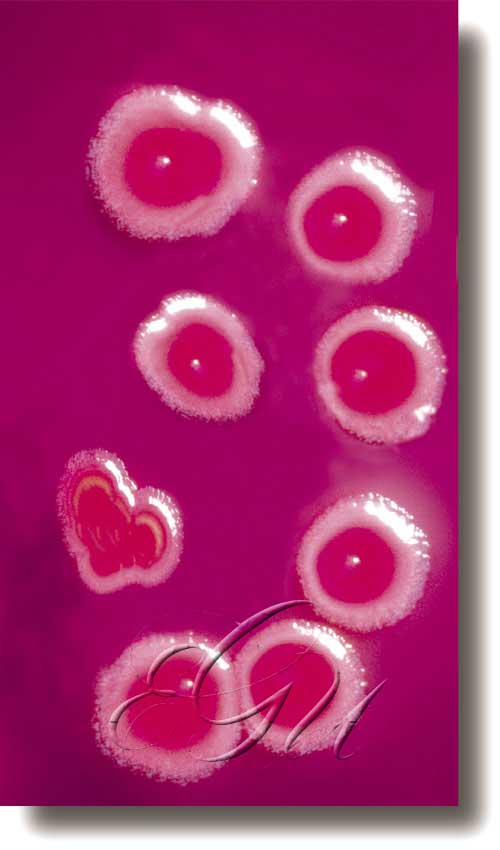

Escherichia
Escherichia
[MONERA]
Xénero de bacterias aerobias Gram-negativas da familia das enterobacteriáceas. Habitantes universais das vías intestinais dos mamíferos, teñen un papel nutricional xa que sintetizan vitaminas, especialmente a vitamina K. A súa presenza nas augas é un indicio de contaminación fecal. Son ocasionalmente patóxenas, sobre todo cando a resistencia do hospedeiro é baixa. A especie característica é a E. coli, coñecida como colibacilo, e é o organismo máis coñecido e máis empregado na investigación biolóxica.